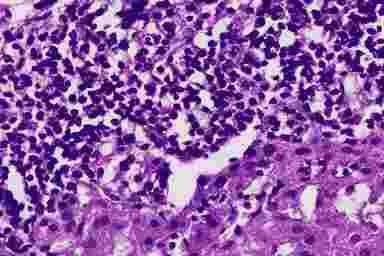
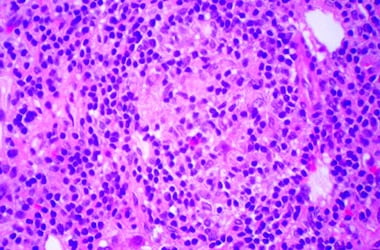

Билиарный цирроз печени — что это такое? Симптомы и лечение
Одним из неприятных заболеваний печени, которое сопровождается нарушением ее функционирования, является биллиарный цирроз. При такой патологии наблюдается разрушение структуры органа в результате сбоев в оттоке желчи, а также изменений строения желчных протоков. Билиарный цирроз печения подразделяется на два вида: первичный и вторичный. Обычно это заболевание диагностируется у людей среднего возраста, однако, чаще всего оно выявляется после 50-60 лет.
Начало заболевания характеризуется развивающейся печеночно-клеточной недостаточностью, которая впоследствии развивается до портальной гипертензии. Прогноз развития заболевания может быть благоприятным, если устранить причину застоя желчи. Если же это невозможно из-за недостаточно квалифицированных докторов или в силу индивидуальных особенностей каждого человека — развивается сильнейшая печеночная недостаточность с нарушением большинства ее функций. Следствие — неминуемый летальный исход.
Что это такое?
Билиарный цирроз печени (БЦП) — это заболевание, при котором по различным причинам нарушается проходимость желчевыводящих протоков, из-за чего отток желчи в кишечник уменьшается или прекращается. По этиологии выделяют первичную и вторичную формы заболевания.
Врачи отмечают, что билиарный цирроз печени является серьезным заболеванием, которое требует внимательного подхода к диагностике и лечению. Специалисты подчеркивают важность раннего выявления болезни, так как на начальных стадиях она может протекать бессимптомно. По мнению врачей, ключевым аспектом в управлении заболеванием является регулярное наблюдение за состоянием пациента и контроль за уровнем печеночных ферментов.
Медики также акцентируют внимание на необходимости комплексного подхода к терапии, который может включать как медикаментозное лечение, так и изменения в образе жизни. Врачи рекомендуют пациентам соблюдать диету, избегать алкоголя и регулярно проходить обследования. Кроме того, они подчеркивают, что поддержка со стороны семьи и близких играет важную роль в процессе лечения и реабилитации. В целом, врачи уверены, что при своевременном обращении за медицинской помощью и соблюдении рекомендаций можно значительно улучшить качество жизни пациентов с билиарным циррозом.
https://youtube.com/watch?v=6tnWIib8cYg
Причины развития
Установить конкретную причину формирования билиарного цирроза до сих пор не удалось. Рассматриваются некоторые теории его формирования:
- наследственная предрасположенность к заболеванию;
- предшествующие инфекционные поражения печени — вирусные, бактериальные, паразитарные;
- токсические повреждения печени;
- аутоиммунное воспаление.
Подтвердить прямую связь между этими состояниями и формированием цирроза на данный момент невозможно.
Сначала под влиянием неких причин лимфоциты начинают уничтожать клетки желчных протоков — в них формируется воспалительный процесс. Вследствие воспаления нарушается проходимость протоков и развивается застой желчи. В этих участках происходит повреждение гепатоцитов и снова развивается воспаление. Массовая гибель клеток способна привести к формированию цирроза.
Классификация
Первичный БЦП — аутоиммунное заболевание, которое проявляется как хроническое негнойное деструктивное воспаление желчных протоков (холангит). На поздних стадиях оно вызывает застой желчи в протоках (холестаз) и со временем провоцирует развитие цирроза печени. Чаще всего от патологии страдают женщины сорока-шестидесяти лет.
- На I стадии воспаление ограничивается желчными протоками.
- На II стадии процесс распространяется на ткань печени.
- III стадия. Гепатоциты — клетки печени — начинают преобразовываться в соединительную ткань, формируются спайки-рубцы, которые «сближают» между собой желчные протоки.
- IV стадия — типичный цирроз печени.
Вторичный билиарный цирроз возникает на фоне длительного нарушения оттока желчи во внутрипеченочных протоках из-за их сужения или закупорки, вызванных другими заболеваниями. Он чаще встречается у мужчин тридцати-пятидесяти лет. Без лечения обе формы заболевания рано или поздно приводят к печеночной недостаточности, ухудшая качество жизни и уменьшая ее продолжительность.
Билиарный цирроз печени — это заболевание, которое вызывает множество обсуждений среди пациентов и врачей. Люди, столкнувшиеся с этой проблемой, часто делятся своими переживаниями и опытом. Многие отмечают, что на начальных стадиях болезнь может протекать бессимптомно, что затрудняет диагностику. Однако по мере прогрессирования заболевания появляются такие симптомы, как усталость, зуд кожи и желтуха.
Некоторые пациенты подчеркивают важность раннего обращения к врачу и регулярного мониторинга состояния печени. В социальных сетях можно встретить множество историй о том, как изменение образа жизни, включая диету и физическую активность, помогло улучшить качество жизни. Также обсуждаются различные методы лечения, включая медикаментозную терапию и, в некоторых случаях, трансплантацию печени.
Общение с другими людьми, страдающими от билиарного цирроза, помогает не только получить полезные советы, но и морально поддержать друг друга в трудные времена.
https://youtube.com/watch?v=hDeKszrl3Yo
Симптомы билиарного цирроза печени
В случае билиарного цирроза симптомы целесообразно группировать по первичной и вторичной форме болезни.
Так, первичный билиарный цирроз характеризуется:
- Окрашивание кожи в темно-коричневый цвет, прежде всего в области лопаток, крупных суставов, а в дальнейшем и всего тела;
- Непостоянным кожным зудом, который чаще появляется во время ночного отдыха, при дополнительных раздражающих факторах (например, после контакта с шерстяными изделиями или после принятия ванны). Зуд может длиться на протяжении многих лет;
- Увеличение селезенки в объёме является частым симптомом болезни;
- Появление плоского образования на веках, имеющего вид бляшки. Их чаще всего несколько, ксантелазмы могут появляться и на груди, ладонях, ягодицах, локтях;
- Человека могут начать беспокоить боли в области правого подреберья, в мышцах, во рту нередко появляется горьковатый привкус, незначительно повышается температура тела.
При прогрессировании болезни все симптомы усиливаются, наблюдается потеря аппетита, кожный зуд становится нестерпимым. Участки пигментации грубеют, кожа отекает, конечные фаланги пальцев утолщаются. Боли усиливаются, наблюдается варикоз вен пищевода и желудка, могут развиваться внутренние кровотечения. Всасывание витаминов и питательных веществ затруднено, присоединяются симптомы гиповитаминоза. Лимфоузлы увеличиваются, происходят нарушения в системе пищеварения.
Вторичная форма заболевания имеет сходные симптомы, среди которых:
- выраженная боль в области поражённой печени;
- интенсивный зуд кожных покровов, усиливающийся в ночное время;
- болезненность печени при пальпации и увеличение её размеров;
- раннее появление желтухи;
- спленомегалия;
- повышение температуры тела до фебрильных показателей на фоне развивающейся инфекции.
Достаточно быстро эта форма заболевания приводит к развитию цирроза и последующей печёночной недостаточности, симптомы которой угрожают жизни пациента. В частности, симптомами развития у человека печёночной недостаточности являются:
- тошнота и рвота кишечным содержимым;
- диспептические расстройства;
- обесцвечивание кала и моча цвета тёмного пива;
- печёночная энцефалопатия (слабоумие).
Состояние может вызвать такие тяжёлые осложнения, как асцит, внутренние желудочные и кишечные кровотечения, кому и смерть.
Диагностика
Диагностические мероприятия по обнаружению первичного билиарного цирроза могут иметь несколько этапов:
- В первую очередь больному с подозрениями на цирроз печени, необходимо проконсультироваться у нескольких врачей — гепатолога, хирурга, гастроэнтеролога. Только они могут выявить болезнь, определить ее степень, назначить последующие диагностические мероприятия и возможное лечение.
- После врачебной консультации, больного с подозрением на цирроз обязательно направляют для сдачи лабораторных анализов. Исследования могут включать в себя развернутый анализ крови и мочи, а также проведение биопсии.
Третья стадия — инструментальная диагностика. Она включает в себя осмотр селезенки, почек, печени, желчевыводящих путей, с помощью проведения УЗИ. Кроме этого проводится осмотр внутренних органов с помощью эндоскопа, введение в кровь и желудочный тракт специальных веществ, которые показывают реальную работу и функционирование печени и желчных протоков.
https://youtube.com/watch?v=mTR8KRpc5U0
Лечение билиарного цирроза
При диагностировании билиарного цирроза методы лечения основаны на снижении интенсивности его симптоматических проявлений, замедление дальнейшего развития, терапии присоединившихся осложнений и профилактики их возникновения.
Курс лечения и подбор препаратов подбирается в индивидуальном порядке Вашим лечащим врачом. В основном назначают:
Гепатопротекторы:
- Урсодезоксихолевая кислота (уросан, урсофальк) по 3 капсулы на ночь, ежедневно.
Иммунодепрессанты (только при первичном билиарном циррозе):
- Метотрексат 15 мг в неделю или циклоспорин в лечебной дозировке по 3 мг на 1 кг массы тела в сутки, разделенный на 2 приема (утро и вечер).
Противовоспалительная терапия:
- Преднизолон по 30 мг 1 раз в сутки утром натощак, через 8 недель доза препарата снижается до 10 мг 1 раз в сутки утром натощак.
Лечение нарушения обмена витаминов и минеральных веществ:
- купренил (D-пеницилламин) по 250 мг, растворенного в одном стакане воды 3 раза в день на 1,5 часа до приема пищи;
- поливитамины (цитрум, мультитабс) по 1 капсуле 1 раз в сутки;
- стимол по 1 пакетику 2 раза в сутки.
Лечение кожного зуда:
- колестирамин (квестран) по 4 мг за 1,5 часа до приема пищи 2 — 3 раза в сутки;
- рифампин (римактан, бенемицин, тибицин) по150 мг 2 раза в сутки;
- антигистаминные препараты (атаракс, супрастин) по 1 — 2 таблетки 2 — 3 раза в сутки.
В случае вторичного билиарного цирроза важно восстановит нормальный отток желчи. Для этого назначается эндоскопия, или хирургическое вмешательство. Если же по каким-то причинам данные манипуляции невозможны, назначаются антибиотики для предотвращения перехода цирроза в термальную стадию.
Среди видов хирургического вмешательства можно выделить такие манипуляции:
- Холедохотомия;
- Холедохостомия;
- Удаление конкрементов из желчных путей;
- Бужирование эндоскопическое;
- Стентирование эндоскопическое;
- Расширение желчных протоков;
- Наружное дренирование протоков желчи.
Пациентам назначается диета №5. К употреблению разрешены овощи, фрукты, соки, компоты, кисель, овощные супы, нежирные виды мяса, каши.
Вопрос-ответ
Сколько живут с первичным билиарным циррозом?
Если уже начали проявляться клинические проявления, то пациенты умирают от печеночной недостаточности уже через 7-8 лет.
Кто обычно болеет первичным билиарным циррозом печени?
Первичный билиарный цирроз печени развивается преимущественно у женщин (соотношение заболевших женщин и мужчин 10:6). Средний возраст пациентов составляет 40-60 лет.
Советы
СОВЕТ №1
Регулярно проходите медицинские обследования. Билиарный цирроз печени может развиваться незаметно, поэтому важно регулярно проверять состояние печени и проходить необходимые анализы, чтобы выявить заболевание на ранней стадии.
СОВЕТ №2
Соблюдайте здоровую диету. Употребление пищи, богатой антиоксидантами, витаминами и минералами, может помочь поддерживать здоровье печени. Избегайте жирной и жареной пищи, а также алкоголя, чтобы снизить нагрузку на печень.
СОВЕТ №3
Обратите внимание на симптомы. Будьте внимательны к изменениям в своем организме, таким как усталость, зуд кожи, желтуха или изменения в стуле. При появлении этих симптомов немедленно обращайтесь к врачу для диагностики и лечения.
СОВЕТ №4
Поддерживайте здоровый образ жизни. Регулярные физические нагрузки и отказ от вредных привычек, таких как курение, могут значительно улучшить общее состояние здоровья и снизить риск осложнений, связанных с билиарным циррозом печени.